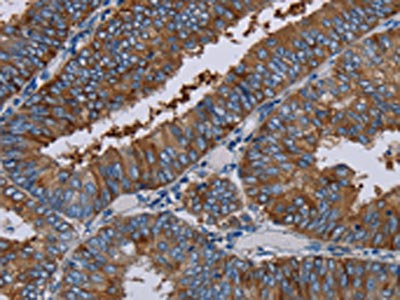

-
中文名稱:EDNRB兔多克隆抗體
-
貨號:CSB-PA093669
-
規格:¥1100
-
圖片:
-
The image on the left is immunohistochemistry of paraffin-embedded Human thyroid cancer tissue using CSB-PA093669(EDNRB Antibody) at dilution 1/30, on the right is treated with synthetic peptide. (Original magnification: ×200)
-
The image on the left is immunohistochemistry of paraffin-embedded Human colon cancer tissue using CSB-PA093669(EDNRB Antibody) at dilution 1/30, on the right is treated with synthetic peptide. (Original magnification: ×200)
-
-
其他:
產品詳情
-
Uniprot No.:
-
基因名:
-
別名:EDNRB; ETRB; Endothelin receptor type B; ET-B; ET-BR; Endothelin receptor non-selective type
-
宿主:Rabbit
-
反應種屬:Human
-
免疫原:Synthetic peptide of Human EDNRB
-
免疫原種屬:Homo sapiens (Human)
-
標記方式:Non-conjugated
-
抗體亞型:IgG
-
純化方式:Antigen affinity purification
-
濃度:It differs from different batches. Please contact us to confirm it.
-
保存緩沖液:-20°C, pH7.4 PBS, 0.05% NaN3, 40% Glycerol
-
產品提供形式:Liquid
-
應用范圍:ELISA,IHC
-
推薦稀釋比:
Application Recommended Dilution ELISA 1:1000-1:2000 IHC 1:50-1:200 -
Protocols:
-
儲存條件:Upon receipt, store at -20°C or -80°C. Avoid repeated freeze.
-
貨期:Basically, we can dispatch the products out in 1-3 working days after receiving your orders. Delivery time maybe differs from different purchasing way or location, please kindly consult your local distributors for specific delivery time.
-
用途:For Research Use Only. Not for use in diagnostic or therapeutic procedures.
相關產品
靶點詳情
-
功能:Non-specific receptor for endothelin 1, 2, and 3. Mediates its action by association with G proteins that activate a phosphatidylinositol-calcium second messenger system.
-
基因功能參考文獻:
- the joint effect of polymorphisms of EDNRB and NOS3 on diabetic retinopathy risk was greater than the individual effect of each polymorphism in the analyzed genetic models PMID: 28817788
- the results suggest that aberrant expression of Gli1 serves a role in HSCR by targeting EDNRB. PMID: 29484400
- Endothelin B receptor (ETBR) is overexpressed in glioblastoma and may be a prognostic marker and useful target for treating cancer patients. PMID: 29409474
- our current findings suggest that human neutrophils display functional ETB receptors with calcium signaling capability, leading to accentuated adhesion to the endothelium. PMID: 28385784
- ETBR function contributes to diminished endothelium-dependent dilation in previously preeclamptic women. PMID: 29042489
- An IL2-targeted antibody failed to detect transfected ETB in HEK293 cultures. In contrast, the NT-targeted antibody accurately detected transfected ETB in HEK293 cultures by labeling a 37-kDa band. PMID: 25232999
- This study concluded that ETB receptors mediate vasodilation in young women, but this effect is lost after menopause. PMID: 28438762
- Our results suggest that EDNRB rs5351 single nucleotide polymorphism is a strong independent predictor of essential hypertension in men of Tatar ethnic origin. PMID: 28350619
- No rare EDNRB variants were identified among 57 patients with Hirschsprung disease. PMID: 26395553
- Taking into account that the cohort we screened was deprived of patients previously found mutated in MITF (about 15%) and SOX10 (another 15%), our 8% mutation rate indicates that EDNRB heterozygous mutations represent about 5%-6% of all WS2, making it the third gene of this subtype. PMID: 28236341
- The high level of ETBR expression observed in CMS patients compared to healthy controls suggests that the cerebral hypoxia diastolic reaction is possible due to ETBR, rather than ET-1 itself. PMID: 27485004
- crystal structures of human endothelin type B receptor in the ligand-free form and in complex with the endogenous agonist endothelin-1 PMID: 27595334
- Wnt-dependent EdnrB signaling can rescue the defects in melanocyte regeneration caused by Mc1R loss. PMID: 27134165
- This article is focused on the engineering, expression, purification, and characterization of the endothelin receptor B for subsequent structural and functional studies PMID: 27193723
- Serum EDNRB hypermethylation is a highly specific but not sensitive serum biomarker for HNSCC PMID: 24995714
- High Endothelin B receptor expression is associated with malignant gliomas. PMID: 26645886
- EDNRB plays a key role in hypoxia tolerance PMID: 26240367
- The increased gene expression of MITF and EDNRB in UVB-exposed NHMs. PMID: 26030901
- culturing of reconstructed skin with microvascular endothelial cells led to increased skin pigmentation that could be prevented by inhibiting EDNRB PMID: 26308584
- Polymorphisms of the EDNRB gene may influence the susceptibility to obesity and can interact with plasma arsenic levels PMID: 25799405
- Cumulative effects of the RET and EDNRB genes contribute to long-segment and total colonic aganglionosis. PMID: 25638620
- Endothelin receptor B expression was significantly lower while higher staining grade was found in basal cell carcinoma rather than squamous cell carcinoma or psoriasis. PMID: 25946671
- Its expression by lymphoma and endothelial cells may mediate trafficking of tumor-infiltrated lymphocytes, which may explain the immune escape processes of primary central nervous system lymphomas. PMID: 25433721
- The results show that MitA can effectively be used to block ETBR mediated vasoconstriction as a supplement to an existing ischemic stroke therapy. PMID: 25479176
- Identification of heterozygous deletion of the entire EDNRB in a father and 2 children. Since heterozygous deletion was the only change identified in EDNRB, the family represents one of the few cases of autosomal dominant inheritance of Waardenburg type 4 PMID: 25118007
- The anti-EDNRB ADC combines well with BRAF and MEK inhibitors and could have therapeutic use in the majority of human melanoma cases. PMID: 24651527
- A novel stop mutation in the EDNRB gene was found in a family with Hirschsprung's disease associated with multiple sclerosis. PMID: 24726125
- No biologically significant correlation was observed in the ETBR immunohistochemistry of human pancreatic ductal adenocarcinoma sections PMID: 24549269
- There was no difference in EDNRB mRNA expression between reflux esophagitis, Barrett's esophagus, and controls. PMID: 23384184
- Hypermethylation of EDNRB promoter contributes to the risk of colorectal cancer. PMID: 24326135
- The endothelin B receptor was demonstrated to mediate the proliferation of oligodendroglioma cells according to an ERK-dependent mechanism. PMID: 24145738
- The -615 to -624 bp region is the key binding site of AP-1 in ETB receptor promoter and was found to be crucial for inducible ETB receptor expression. PMID: 24265756
- The levels of the EDNRB, HJURP and p60/CAF-1 proteins were strongly associated with overall survival in high-grade gliomas patients (p<0.001, p<0.001 and p=0.002, respectively), whereas the one of PDLI4 was not (P=0.11). PMID: 24039914
- Gene expression profiling for uveal melanoma may be obtained from patients who were previously treated with radiotherapy PMID: 24511587
- Endothelin receptor type B expression was correlated with several clinicopathological factors including tumor differentiation, tumor depth, and lymph node metastasis. PMID: 24357795
- EDNRB is generally accepted as a major gene for Hirschsprung's disease. PMID: 23579558
- Endothelin receptor type B is a novel pathway and therapeutic target for enhancing remyelination in multiple sclerosis. PMID: 23518706
- Expression of endothelin A and B receptors and endothelin-1 in the pulmonary arteries is significantly increased in failed Fontan patients. PMID: 21356562
- Data indicate that endothelin receptor B (EDNRB) overexpression facilitates intracranial melanoma growth. PMID: 22865454
- Our findings demonstrate that aldosterone modulates an ET(B) cysteinyl thiol redox switch to decrease pulmonary endothelium-derived NO(.) and promote pulmonary arterial hypertension. PMID: 22787113
- Loss of EDNRB is associated with metastasis in clear-cell renal cell carcinoma. PMID: 22213152
- results obtained give evidence of a possible participation of receptor for endothelin B in the pathogenesis of the itch in the dermatitis herpetiformis PMID: 22535604
- promoter hypermethylation of EDNRB gene is highly prevalent in gastric cancer PMID: 21264540
- In transgenic Ednrb-deficient mice, sacral crest-derived cells diminish in number from fetal to postnatal stages. PMID: 21858821
- Survival analysis shows that the ETB receptor high expression group had significantly shorter disease-free survival and overall survival rates than the low expression group. PMID: 21770857
- Attenuated ET-B receptor mediated vasodilatation during local skin warming compared to Controls. PMID: 21825025
- 3 novel mutations in EDNRB gene associated with Waardenburg-Shah syndrome (WS4) in Pakistani patients. PMID: 21547364
- No association of S305N EDNRB polymorphism with sporadic melanoma risk in the French or Italian populations, but there was an indication that EDNRB might be a melanoma-predisposing gene in French patients with a hereditary predisposition to melanoma. PMID: 21507037
- Endothelin type B receptor-mediated contractions of the cerebrovasculature are significantly reduced following inhibition of B-raf kinase. PMID: 21223556
- cigarette smoke extract induced ET(B) receptor overexpression by a feed forward mechanism mediated partly by ET release, promoting pulmonary artery endothelial cell dysfunction and attenuated by ET(B) receptor blockade, Rho kinase and ROS inhibition PMID: 20698855
顯示更多
收起更多
-
相關疾病:Waardenburg syndrome 4A (WS4A); Hirschsprung disease 2 (HSCR2); ABCD syndrome (ABCDS)
-
亞細胞定位:Cell membrane; Multi-pass membrane protein.
-
蛋白家族:G-protein coupled receptor 1 family, Endothelin receptor subfamily, EDNRB sub-subfamily
-
組織特異性:Expressed in placental stem villi vessels, but not in cultured placental villi smooth muscle cells.
-
數據庫鏈接:
Most popular with customers
-
YWHAB Recombinant Monoclonal Antibody
Applications: ELISA, WB, IHC, IF, FC
Species Reactivity: Human, Mouse, Rat
-
Phospho-YAP1 (S127) Recombinant Monoclonal Antibody
Applications: ELISA, WB, IHC
Species Reactivity: Human
-
-
-
-
-
-